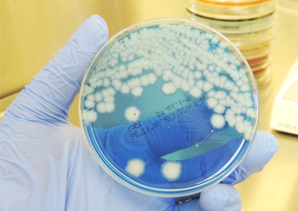

臨床検査部では、信頼のおける検査結果を報告するため日々機器管理や精度管理を徹底して行っています。
特により正確な結果を届けるため外部機関による精度管理にも多数参加し評価されています。

臨床工学技士として炎症性腸疾患(潰瘍性大腸炎)の患者さんの白血
球除去療法(LCAP)、顆粒球吸着療法(GCAP)の治療に参加。
| 機種名称 | メーカー | 数量 |
|---|---|---|
| 免疫血清分野機器 | ||
| 化学発光免疫測定装置 ルミパルスG-1200 | 富士レビオ | 1台 |
| 全自動化学発光免疫測定装置 ARCHTECTアナライザーi2000SR | アボットジャパン | 1台 |
| 臨床化学分野機器 | ||
| 臨床化学自動分析装置 TBA-c16000 | 東芝メディカルシステムズ | 1台 |
| ディスクリート方式臨床化学自動分析装置 ヘモテクト NS-Prime | アルフレッサファーマ | 1台 |
| 乾式臨床化学分析装置 DRI-CHEM | 富士フイルム | 1台 |
| 分光光度計 臨床検査用分光光度計 | 日立 | 1台 |
| 遠心機 テーブルトップ遠心機4000 | クボタ | 3台 |
| グリコヘモグロビン分析装置 | 東ソー | 1台 |
| 血液分野機器 | ||
| 多項目自動血球分析装置 XT-2000i | シスメックス | 1台 |
| 多項目自動血球分析装置 XT-1800i | シスメックス | 1台 |
| 赤血球沈降速度測定装置 VES-MATIC | LMS | 1台 |
| 全自動血液凝固測定装置 CAシリーズ | シスメックス | 1台 |
| 全自動pH/血液ガス分析装置 GASTAT | テクノメディカ | 1台 |
| 一般検査・輸血分野機器 | ||
| 尿自動分析装置 US-2200 | 栄研化学 | 2台 |
| 自己血チューブ作成装置 チューブシーラー | テルモ | 1台 |
| 自動血球洗浄機 | 日立 | 1台 |
| 検査システム | ||
| 検体検査システム Lavital-LS | シスメックスCAN | 15台 |
| 全自動採血管準備装置 BC-ROBO | テクノメディカ | 1台 |
| ハルンカップラベラー HARN | テクノメディカ | 1台 |
| 細菌分野機器 | ||
| 細菌同定感受性検査測定装置 VITEK2 | シスメックス | 1台 |
| 全自動血液培養・抗酸菌培養装置 BACT/ALERT 3D 60 | シスメックス | 1台 |
| 赤外分光分析装置 POC one | フクダ電子 | 1台 |
| 顕微鏡 | オリンパス | 4台 |
| 顕微鏡用LED蛍光モジュール | オリンパス | 1台 |
| 顕微鏡用写真撮影装置 | オリンパス | 2台 |
| ふ卵機 | サクラ精機 | 1台 |
| 恒温インキュベーター IS401 | ヤマト科学 | 1台 |
| 細菌検査システム Lavital-MS | シスメックスCAN | 1台 |
| バイオハザード対策用クラスⅡキャビネット | ダルトン | 1台 |
| 乾熱滅菌機 HOT-AIR STERILIZER | サクラ精機 | 1台 |
| 高圧滅菌機 | ヤマト科学 | 1台 |
| 生理分野機器 | ||
| 心電計 | 日本光電 | 5台 |
| 長時間心電用データレコーダー | 日本光電 | 1台 |
| オージオメーター | リオン | 1台 |
| 肺機能検査装置 DISCOM-21 FXⅡ | チェスト | 2台 |
| 無散瞳眼底カメラ CR-2 | キヤノン | 1台 |
| 無散瞳眼底カメラシステム GT-FINDER | キヤノン | 1台 |
| 非接触眼圧計 TX-20P | キヤノン | 1台 |